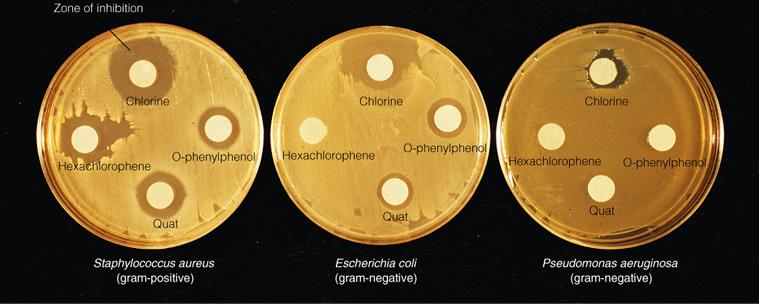

THE TERMINOLOGY OF MICROBIAL CONTROL
Aseptic Surgery
Techniques used in surgery to prevent microbial contamination from the instruments, operating personnel, and the patient.
THE TERMINOLOGY OF MICROBIAL CONTROL
Sterilization
The destruction or removal of all microbial life, including endospores.
THE TERMINOLOGY OF MICROBIAL CONTROL
How do you sterilize liquids or gases?
By using filtration.
THE TERMINOLOGY OF MICROBIAL CONTROL
Sterilant
Is a sterilizing agent.
THE TERMINOLOGY OF MICROBIAL CONTROL
Commercial Sterilization
The process of treating canned goods aimed at destroying the endospores of Clostridium botulinum (a kind of food poisoning).
THE TERMINOLOGY OF MICROBIAL CONTROL
Why is commercial sterilization important?
Clostridium botulinum produces a deadly toxin. More-resistant endospores of thermophilic (heat-loving) bacteria are capable of causing food spoilage but not human disease, and they will not germinate and grow at normal food storage temperatures.
THE TERMINOLOGY OF MICROBIAL CONTROL
Disinfection
Any treatment used on inanimate objects to kill or inhibit the growth of microorganisms; removing pathogens.
THE TERMINOLOGY OF MICROBIAL CONTROL
Antisepsis
A chemical method for disinfection of the skin and mucous membranes; removing pathogens from living tissues.
THE TERMINOLOGY OF MICROBIAL CONTROL
Antiseptic
Is the chemical used to perform the antisepsis technique.
THE TERMINOLOGY OF MICROBIAL CONTROL
Sepsis
The presence of a toxin or pathogenic organism in blood and tissue; refers to microbial contamination.
THE TERMINOLOGY OF MICROBIAL CONTROL
Asepsis
The absence of contamination by unwanted organisms.
THE TERMINOLOGY OF MICROBIAL CONTROL
Degerming
The mechanical removal of microorganisms in an area or injection site, rather than killing them; also called degermation.
THE TERMINOLOGY OF MICROBIAL CONTROL
Sanitization
The removal of microorganisms from eating utensils and food preparation areas.
Biocide, or Germicide
A substance capable of killing microorganisms (except endospores).
THE TERMINOLOGY OF MICROBIAL CONTROL
Suffix -cide
Names of treatments that cause the outright death of microbes; meaning kill.
Bacteriostasis
A treatment capable of inhibiting bacterial growth.
EFFECTIVENESS OF TREATMENT
Depends on:
1. The number of microbes.
2. Environment (organic matter, temperature,
biofilms).
3. The time of exposure.
4. Microbial characteristics.
ACTION OF MICROBIAL CONTROL AGENTS
1. Alterations of membrane permeability.
2. Damage to proteins.
3. Damage to nucleic acids.
HEAT
Thermal death point (TDP)
The temperature required to kill all the bacteria in a liquid culture in 10 minutes.
HEAT
Thermal death time (TDT)
The length of time required to kill all bacteria in a liquid culture at a given temperature.
HEAT
Decimal reduction time (DRT)
The time (in minutes) required to kill 90% of a bacterial population at a given temperature; also called D value.
MOIST HEAT STERILIZATION
Moist heat denatures proteins.
MOIST HEAT STERILIZATION
Autoclave
Equipment for sterilization by steam under pressure; usually operated at 15 psi and 121°C to kill all organisms (except prions)and their endospores in about 15 minutes; guaranteed complete sterilization.
Pasteurization
The process of mild heating to kill particular spoilage microorganism or pathogens; normal pasteurization is 63°C for 30 minutes; does not achieve complete sterilization only reduces microbes.
PASTEURIZATION
1. Reduces spoilage organisms and pathogens.
2. EQUIVALENT TREATMENTS:
a) 63°C for 30 min
b) High-temperature short-time
c) Ultra-high-temperature
d) Thermoduric organisms survive
PASTEURIZATION
High-temperature short-time (HTST) pasteurization
Pasteurization at 72°C for 15 seconds.
PASTEURIZATION
Ultra-high-temperature (UHT)treatments
A method of treating food with high temperatures (140-150°C for 4 seconds) for very short times to make food sterile so that it can be stored at room temperature.
What are the differences between HTST and UHT?
1. HTST is pasteurization and has to be
refrigerated for a certain amount of time
(usually 2 weeks) before it spoils.
2. UHT is sterilized and can be stored for several
months without refrigeration; an example is
the small coffee creamers found in restaurants.
Thermoduric bacteria
Heat resistant; survive pasteurization; unlikely to cause disease or cause refrigerated milk to spoil.
DRY HEAT STERILIZATION
Kills by:
1. Dry heat
2. Flaming
3. Incineration
4. Hot-air sterilization
DRY HEAT STERILIZATION
Dry heat
Kills by oxidation effects.
DRY HEAT STERILIZATION
Flaming
The process of sterilizing an inoculating loop by holding it in an open flame.
DRY HEAT STERILIZATION
Incineration
Burning to ashes.
DRY HEAT STERILIZATION
Hot-air sterilization
Sterilization by the use of an oven at 170°C for approximately 2 hours.
DRY HEAT STERILIZATION
Equivalent treatments
Different methods that have the same effect on controlling microbial growth.
FILTRATION
The passage of a liquid or gas through a screenlike material; a 0.45µm filter removes most bacteria; heat labile (sensitive)substances should be sterilized by filtration and not heat.
FILTRATION
High-efficiency particulate air (HEPA) filters
A screenlike material that removes particles greater than 0.3µm from air.
FILTRATION
Membrane filters
A screen-like material with pores small enough to remove microbes greater than 0.22µm from air; a 0.45µm filter retains most bacteria; used for liquids.
FILTRATION
Filterable viruses
Unseen pathogens that passed through the filters (causing such disease as rabies) made of unglazed porcelain in the early days of microbiology.
PHYSICAL METHODS OF MICROBIAL CONTROL
Kills by:
1. Low temperature
2. High pressure
3. Desiccation
4. Osmotic pressure
PHYSICAL METHODS OF MICROBIAL CONTROL
Low temperature
1. Creates a bacteriostatic effect at temperatures of ordinary refrigerators (0-7°C) because it reduces the metabolic rate of most microbes so that they cannot reproduce or synthesize toxins; rapidly attained subfreezing temperatures tend to render microbes dormant but do not necessarily kill them.
2. INHIBITS MICROBIAL GROWTH:
a) Refrigeration
b) Deep-freezing
c) Lyophilization
PHYSICAL METHODS OF MICROBIAL CONTROL
Lyophilization
In the absence of water (desiccation) microorganisms cannot grow or reproduce but can remain viable for years and then resume their growth and division once water is made available to them; also called freeze-drying, which is a laboratory process for preserving microbes.
PHYSICAL METHODS OF MICROBIAL CONTROL
High pressure
Denatures proteins
PHYSICAL METHODS OF MICROBIAL CONTROL
Desiccation
The removal of water; drying; prevents metabolism.
PHYSICAL METHODS OF MICROBIAL CONTROL
Osmotic pressure
High concentrations of salt and sugars causes PLASMOLYSIS which is the loss of water from a cell in a hypertonic environment; can't metabolize but inhibits their growth
RADIATION
Types:
1. Ionizing radiation
2. Nonionizing radiation
3. Microwaves
RADIATION
Ionizing radiation
1.Gamma rays, X rays, or High-energy electron
beams, has a wavelength shorter than that of
nonionizing radiation less than about 1nm.
2. Ionizes water to release OH.
3. Damages DNA.
RADIATION
Non-ionizing radiation
1. Short-wavelength radiation that does not cause
ionization; radiation is not very penetrating;
ultraviolet (UV) radiation (260nm) is an
example.
2. Damages DNA.
RADIATION
Microwaves
1. Electromagnetic radiation.
2. Kill by radiation; not especially antimicrobial.
PRINCIPLES OF EFFECTIVE DISINFECTION
1. Concentration
2. Organic matter
3. pH
4. Time
USE-DILUTION TEST
1. A method of determining the effectiveness of a
disinfectant using serial dilutions.
2. Metal rings dipped in test bacteria are dried.
3. Dried cultures are placed in disinfectant for 10 min at 20°C.
4. Rings are transferred to culture media to
determine whether bacteria survived treatment.
DISK-DIFFUSION METHOD
An agar-diffusion test to determine microbial susceptibility to chemotherapeutic agents; also called Kirby-Bauer test.
Phenol
Also called carbolic acid; first used by Lister to control surgical infections in the operating room.
Phenolics
A derivative of phenol used as a disinfectant.
PHENOL & PHENOLICS
Disrupt plasma membranes
Cresol
Phenolic derived from coal tar; are very good surface disinfectants.
Why are phenolics useful as disinfectants?
1. They remain active in the presence of organic
compounds.
2. They are stable.
3. They persist for long periods after
application.
Bisphenols
1. A derivative of phenol that contains two phenol
groups connected by a bridge (bis indicates
two).
2. HEXACHOLORPHENE, TRICLOSAN:
disrupt plasma membrane
Hexachlorophene
A type of bisphenol used to control infections in nurseries; excessive use on infants can lead to nerve damage.
Triclosan
A bisphenol used in antibacterial soaps, at least one toothpaste, and kitchen cutting boards and plastics; it inhibits an enzyme needed for the biosynthesis of fatty acids (lipids), which mainly affects the plasma membrane; effective againt gram positive bacteria and also works well against gram-negative bacteria.
Biguanides
CHLORHEXIDINE:
disrupt Plasma membrane
Chlorhexidine
A Biguanide used for microbial control on skin and mucous membranes.
Fungicide
A substance capable of killing fungi.
Virucide
A substance capable of inactivating viruses.
Suffix -stat or -stasis
Names of treatments that inhibit the growth and multiplication of bacteria; meaning to stop or to steady.
Several factors influence the effectiveness of antimicrobial treatments:
1. The number of microbes
2. Environmental influences:
a. Organic matter
b. Microbes in surface biofilms
c. Suspended medium
3. Time of exposure
4. Microbial characteristics
The number of microbes
The more microbes there are to begin with, the longer it takes to eliminate the entire population.
Environmental influences
Organic matter
Inhibits the action of chemical antimicrobials.
Environmental influences
Microbes in surface biofilms
Are difficult for biocides to reach effectively. Because their activity is due to temperature-dependent chemical reactions, disinfectants work somewhat better under warm conditions.
Environmental influences
Suspended in medium
Fats and proteins are especially protective, and a medium rich in these substances protect microbes, which will then have a higher survival rate.
Time of exposure
Chemical antimicrobials often require extended exposure to affect more-resistant microbes or endospores.
Microbial characteristics
Affect the choice of chemical and physical control methods.
Cell membrane permeability
This membrane actively regulates the passage of nutrients into the cell and the elimination of waste from the cell.
Functional properties of proteins
Are the result of their three-dimensional shape.
What physical methods are used as heat techniques?
1. Moist heat:
a) Boiling or flowing stream
b) Autoclaving
2. Pasteurization
3. Dry heat:
a) Direct flaming
b) Incineration
c) Hot-air sterilization
Retorts
A device for commercially sterilizing canned food by using steam under pressure; operates on the same principle as an autoclave but is much larger.
Boiling or flowing stream
Kills vegetative forms of bacterial pathogens, almost all viruses, and fungi and their spores within about 10 minutes; 100°C is considered boiling; does not kill endospores so it is not considered a complete sterilization.
What does the phosphate test, test for?
**phosphatase is an enzyme naturally present in milk**
To determine whether products have been pasteurized; phosphatase products will be inactived if the product has been pasteurized.
What types of bacteria and what types of virus can resist boiling? And for how long?
1. Some hepatitis viruses, can resist up to 30
minutes of boiling.
2. Some bacterial endospores, can resist boiling
for more than 20 hours.
Sterilization in an autoclave is most effective when?
1. The organisms are contacted by the steam
directly.
2. Or contained in a small volume of aqueous
(primarily water) liquid.
What physical methods are used as cold techniques?
1. Refrigeration
2. Deep-freezing
3. Lyophilization
Halogens
One of the following elements: fluorine, chlorine, bromine, iodine, or astatine.
HALOGENS-IODINE
Tincture
A solution in aqueous alcohol and is an iodophor.
HALOGENS-IODINE
Iodophors
A combination of iodine and an organic molecule, from which the iodine is released slowly; have the antimicrobial activity of iodine, but they do not stain and are less irritating.
HALOGENS
Chlorine
1. BLEACH:
Hypochlorous acid (HOCI)
2. CHLORAMINE:
Chlorine + ammonia
3. Oxidizing agents
Alcohols
1. An organic molecule with the functional group-
OH.
2. ETHANOL, ISOPROPANOL:
a) denature proteins, dissolve lipids
b) require water
Pseudomonas aeruginosa
A gram-negative bacteria that is very resistant to triclosan, and many other antibiotics and disinfectants.
HEAVY METALS
Ag, Hg, Cu
1. Silver Nitrate may be used to prevent
gonorrheal opthalmia neonatorum.
2. Silver Sulfadiazine used as a topical cream on
burns.
3. Copper Sulfate is an algicide.
HEAVY METALS
Oligodynamic action
The ability of small amounts of a heavy metal compound to exert antimicrobial activity; oligo means few; denatures proteins.
SURFACE-ACTIVE AGENTS, OR SURFACTANTS
Surface-active agents
Any compound that decreases the tension between molecules lying on the surface of a liquid; also called surfactant.
SURFACE-ACTIVE AGENTS, OR SURFACTANTS
Soap
Degerming
SURFACE-ACTIVE AGENTS, OR SURFACTANTS
Acid-anionic detergents
Sanitizing
SURFACE-ACTIVE AGENTS, OR SURFACTANTS
Quaternary ammonium compounds (cationic detergents)
Bactericidal, denature proteins, disrupt plasma membrane.
Quaternary ammonium compounds (quats)
A cationic detergent with four organic groups attached to a central nitrogen atom; used as a disinfectant; are less effective against gram-negative bacteria and more effective against gram positive bacteria.
Sulfar dioxide ( SO₂)
Disinfectant used in wine-making.
Sorbic acid, potassium sorbate, sodium benzoate
Prevent molds from growing on acidic foods, such as cheese and soft drinks.
Calcium propionate
An effective fungistat used in bread, prevents the growth of surface molds and the Bacillus bacterium that causes ropy bread.
Sodium nitrate and Sodium nitrite
Are added to many meat products, such as ham, bacon, hot dogs, and sausage.
How do the bacteria in meats use nitrate?
As a substitute for oxygen under anaerobic conditions.
What are the 2 main functions of nitrite?
1) To preserve the red color of the meat by reacting with blood components in the meat.
2) To prevent the germination and growth of any botulism endospores that might be present.
Nitrosamines
A carcinogen formed by the combination of nitrite and amino acids.
ALDEHYDES
1. An organic molecule with the functional group-
CHO.
2. Inactivates proteins by cross-linking with
functional groups (-NH₂, -OH, -COOH, -SH)
3. USE: MEDICAL EQUIPMENT
a) Glutaraldehyde, formaldehyde, and ortho-
phthalaldehyde.
GASEOUS STERILANTS
1. Denature proteins
2. USE: HEAT-SENSITIVE MATERIAL
a) Ethylene oxide
PLASMA
1. The liquid portion of blood in which the formed
elements are suspended.
2. Exited gases used for sterilization.
3. Free radicals destroy microbes.
4. USE: TUBULAR INSTRUMENTS
SUPERCRITICAL FLUIDS
1. CO₂with gaseous and liquid properties.
2. USE: MEDICAL IMPLANTS
PEROXYGENS
1. A class of oxidizing-type sterilizing
disinfectants.
2. Oxidizing agents.
3. USE: CONTAMINATED SURFACES
a) O3, H₂O₂, peracetic acid
CHEMICAL FOOD PRESERVATIVES
ORGANIC ACID
1. Inhibits metabolism.
2. Sorbic acid, benzoic acid, and calcium
propionate.
3. Control molds and bacteria in foods and
cosmetics.
CHEMICAL FOOD PRESERVATIVES
Nitrite
Prevents endospore germination.
CHEMICAL FOOD PRESERVATIVES
Antibiotics
Nisin and Natamycin prevent spoilage of cheese.
Nisin
Is often added to cheese to prevent the growth of certain endospore-forming spoilage bacteria.
Natamycin (primaricin)
Is an antifungal antibiotic approved for use in foods, mostly cheese.
MICROBIAL CHARACTERISTICS
IN ORDER FROM MOST RESISTANT TO LEAST RESISTANT:
Prions
Endospores of bacteria
Mycobacteria
Cysts of protozoa
Vegetative protozoa
Gram-negative bacteria
Fungi, including most fungal spores
Viruses without envelopes
Gram-positive bacteria
Viruses with lipid envelopes
Sterilization is the:
A) same as sanitization.
B) destruction of all forms of microbial life
except endospores.
C) effective removal of all microbes on a
surface.
D) destruction of all life forms.
E) control of all microbial growth.
Destruction of all life forms.
An antiseptic is used when one needs to remove microbes from:
A) food preparation areas.
B) foods, prior to canning.
C) toilet surfaces.
D) restaurant glassware.
E) skin, prior to injection.
Skin, prior to injection.
Foods to be canned need not be sterile. However, all ______ of Clostridium botulinum must be killed.
A) LPS
B) capsules
C) flagellar proteins
D) cells
E) endospores
Endospores
Some antimicrobial treatments kill microbes; some inhibit growth. Which term refers to an agent that inhibits bacterial growth?
A) Germicidal.
B) Bacteriostatic.
C) Fungicidal.
D) Homeostatic.
E) Bacteriocidal.
Bacteriostatic.
Which of the following is not a major target for action of antimicrobials?
A) Flagella.
B) Enzymes
C) Nucleic acids.
D) Cell membranes.
E) Proteins.
Flagella.
Decimal reduction time is the time in minutes in which _______ of the population at a given temperature will be killed.
A) 75%
B) 100%
C) 10%
D) 80%
E) 90%
90%
Which is not a characteristic of the autoclave?
A) The ability to sterilize solutions with
endospores.
B) The use of high temperatures.
C) The use of moist heat.
D) The use of high pressures.
E) The requirement for long (hours) exposure
times.
The requirement for long (hours) exposure times.
Milk that you have never opened spoils in the refrigerator. A sample reveals the presence of microorganisms. The most likely explanation is:
A) the pasteurization process was ineffective.
B) the microbes are pathogens.
C) the microbes that survived pasteurization were
able to grow at 4 °C.
D) there was a leak in the milk carton that
allowed microbes to enter.
E) pasteurization resistant mutants developed
after pasteurization.
the microbes that survived pasteurization were able to grow at 4 °C.
Pasteurization was first used by Pasteur to control spoilage of:
A) canned foods.
B) cheese.
C) wine.
D) milk.
E) yogurt.
Wine.
Choose the best method for the sterilization of an enzyme solution.
A) Filtration.
B) Freezing.
C) Autoclave
D) Pasteurization.
E) Dry heat.
Filtration.
The bactericidal effect of UV light is attributed to damage to:
A) plasma membranes.
B) proteins.
C) nuclei.
D) DNA.
E) ribosomes.
DNA.
Packages of milk and coffee creamers may be stored without refrigeration if they have been sterilized by:
A) autoclaving.
B) high-temperature short-time (HTST)
pasteurization.
C) boiling.
D) ultra-high-temperature (UHT) treatment.
E) treatment with phenol.
Ultra-high-temperature (UHT) treatment.
All of the following methods are used for food preservation except:
A) Direct flaming.
B) Dessication.
C) Osmotic pressure.
D) Commercial canning.
E) Deep freezing.
Direct flaming.
Some microbes are very resistant to antimicrobial chemicals. Which of the following would be the easiest to kill?
A) E. coli.
B) Cysts of protozoa
C) Pseudomonas aeruginosa
D) Mycobacterium tuberculosis
E) Clostridium endospores
E. coli.
Which type of radiation is least effective in killing microbes?
A) Microwaves
B) Gamma rays
C) Ultraviolet rays
D) High-energy electron beams
E) X rays
Microwaves
The first disinfectant used by Lister was ________.
A) iodine.
B) chlorine.
C) Listerine.
D) Betadine.
E) phenol.
Phenol.
Alcohol is most effective when used as a solution.
A) 70%
B) 60%
C) 25%
D) 95%
E) 100%
70%
All of the following are examples of microbial control using heavy metals except:
A) antiseptic solution containing mercurochrome.
B) benzoyl peroxide used for acne treatment.
C) algae control in swimming pools using copper
sulfate.
D) burn treatment using silver-sulfadiazine
ointment.
E) mouthwash solution containing zinc chloride.
Benzoyl peroxide used for acne treatment.
______ is a compound found in antimicrobial soaps that targets gram-positive bacteria.
A) Formaldehyde
B) Hydrogen peroxide
C) Sodium nitrate
D) Triclosan
E) Mercuric chloride
Triclosan.
The following may be listed on the ingredients of your favorite snack food. Which of the following is not antimicrobial?
A) Xanthan.
B) Calcium propionate.
C) Potassium sorbate.
D) Sorbic acid.
E) Sodium benzoate.
Xanthan.
Microbes vary with respect to sensitivity to an antimicrobial agent.
True.
The presence of organic matter, such as blood or saliva, speeds the action of antimicrobial chemicals.
False.
All bacteria die at once when they are exposed to heat or chemical treatment.
True.
Times required for sterilization in an autoclave are shorter than those required in a dry oven because moist heat penetrates biological specimens more effectively than does dry heat.
True.
Ethylene oxide gas is used to sterilize medical equipment that might be damaged by exposure to the heat of autoclaving.
True.
UV radiation and X ray radiation are similar in that they damage DNA and have a high penetrating power.
False.
Iodine is one of the least effective antimicrobial chemicals, effective only against certain very sensitive strains of bacteria.
False.
Soap is ineffective in killing bacteria. Therefore, hand washing is a rather ineffective measure in preventing disease transmission.
False.
Most disinfectants can be used as antiseptics.
False.
70% ethyl alcohol is a more effective bactericide than 100% alcohol.
True.

According to the figure, at what rate are the cells dying?
A) 1% each minute
B) 10% each minute
C) 50% each minute
D) 90% each minute
E) 99% each minute
90% each minute

In the figure shown, what is the method of sterilization used?
A) Autoclave
B) High pressure
C) Osmotic pressure
D) Radiation
E) Filtration
Filtration
In the photo shown, it can be concluded that the quaternary ammonium compound (Quat) was most effective against:
A) It is impossible to determine from the photo
B) Staphylococcus aureus
C) They are all equally affected by the quat
D) Escherichia coli
E) Pseudomonas aeruginosa
Staphylococcus aureus

All of the following conclusions are correct regarding the photos of the disk-diffusion assay EXCEPT:
A) Gram-negative bacteria are the most sensitive
to the chemicals.
B) Only one of the four chemicals affected
pseudomonas.
C) Gram-positive bacteria are the most sensitive
to the chemicals.
D) Hexachlorophene was effective against gram-
positive bacteria only.
E) Chlorine was effective against all the test
bacteria.
Gram-negative bacteria are the most sensitive to the chemicals.

All of the following conclusions are correct regarding the graph shown EXCEPT:
A) The tincture of iodine was the most effective
chemical agent.
B) Soap and water were shown to be the least
effective chemical agent.
C) By 2 minutes, 70% ethanol and 30% water had
killed 90% of the bacteria.
D) Aqueous Zephiran is more effective than the
tincture of Zephiran.
Aqueous Zephiran is more effective than the tincture of Zephiran.

The clear zones around the coins on the plate in the photo are due which phenomenon?
A) The triclosan in the coins.
B) The oligodynamic action of the metals in the
coins.
C) The halogens present in the coins.
D) The surfactants in the coins.
E) The quaternary ammonium compounds in the coins.
The oligodynamic action of the metals in the coins.

Which chemical shown is a common ingredient in antibacterial soaps and at least one toothpaste?
A) Benzalkonium chloriede (Zephiran)
B) Triclosan
C) Hexachlorophene
D) Phenol
Triclosan
You discover a compound that you suspect reduces spoilage in fruit. You treat apples with your compound and inoculate them with Botrytis, a common spoilage fungus. After seven days the dry weight of fungi on the treated apples is 5 mg and 10 mg on the untreated apples. You conclude from these results that:
A) the compound is toxic to humans.
B) the compound is fungistatic.
C) apple spoilage is caused by fungi.
D) the compound kills fungi.
The compound is fungistatic.
You contaminate kitchen counters with Salmonella enterica in chicken blood and expose it to a variety of treatments to study the survival of the bacteria on kitchen surfaces. The following DRT values were obtained: 2.0 min. at 52° C; 3.7 min. at pH 2.6; 13.3 min. with 10mM hydrogen peroxide; and >35 days without treatment. Which treatment is most effective against S. enterica?
A) acid
B) heat
C) a, b, and c are equivalent treatments
D) hydrogen peroxide
Heat.
The best definition of sterilization is the:
A) removal of all microorganisms.
B) elimination of bacteria.
C) removal of unwanted microorganisms.
D) removal of Clostridium botulinum endospores.
Removal of all microorganisms.
What is the difference between a disinfectant and an antiseptic?
A) Disinfectants kill some microorganisms;
antiseptics kill all microorganisms.
B) Disinfectants kill microorganisms; antiseptics
inhibit microbial growth.
C) Disinfectants are used on environmental
surfaces; antiseptics are used on living
tissue.
D) Disinfectants remove all microorganisms;
antiseptics remove some microorganisms.
Disinfectants are used on environmental surfaces; antiseptics are used on living tissue.
Which of the following treatments achieves sterilization?
A) pasteurization
B) boiling
C) autoclaving
D) commercial sterilization
Autoclaving.
Which one of the following is not an antiseptic?
A) iodine
B) alcohol
C) bispenol
D) soap
Soap.
Which one of the following kills cells by damaging DNA?
A) deep-freezing
B) ultraviolet light
C) alcohol
D) pasteurization
Ultraviolet light.
Which one of the following does not belong with the others?
A) bisphenol
B) iodine
C) chlorine
D) phenolic
Chlorine.
Which one of the following is not an antiseptic?
A) mercurochrome
B) iodine
C) hydrogen peroxide
D) alcohol
Hydrogen peroxide.
Which one of the following methods is bactericidal?
A) deep-freezing
B) filtration
C) lyophilization
D) none of these are bactericidal
None of these are bactericidal.
Which one of the following is effective against bacterial endospores?
A) biguanide
B) hexachlorophene
C) chlorine bleach
D) mercury
Chlorine bleach.
Which one of the following concentrations of ethyl alcohol is the most effective disinfectant?
A) 50%
B) 25%
C) 75%
D) 100%
75%
Four compounds are tested for their disinfectant activity. Compound A kills pseudomonads, mycobacteria, endospores, lipophilic viruses, and hydrophilic viruses. Compound B kills pseudomonads, mycobacteria, and lipophilic viruses. Compound C kills pseudomonads and lipophilic viruses. Compound D does not kill any of the test organisms. Which compound is most likely a soap?
A) Compound C
B) Compound B
C) Compound A
D) Compound D
Compound D.
Which of the following is not an oxidizing agent?
A) chlorine
B) hydrogen peroxide
C) triclosan
D) ozone
Triclosan.
Which one of the following is most useful for disinfecting medical instruments?
A) iodine
B) mercurochrome
C) alcohols
D) glutaraldehyde
Glutaraldehyde.
Which one of the following is generally the easiest to kill?
A) lipophilic viruses
B) hydrophilic viruses
C) Pseudomonas
D) endospores
Lipophilic viruses.
The use-dilution values for three disinfectants tested under the same conditions are: Disinfectant X- 1:10; Disinfectant Y-1:100; Disinfectant Z- 1:1,000. If the disinfectants are non-toxic and designed for the same purpose, which would you select?
A) They are equivalent treatments; it doesn't
matter.
B) Y
C) X
D) Z
Z.
The disk-diffusion test is used to test disinfectants against Staphylococcus aureus. For Disinfectant A, a 1:10 dilution gives a 25 mm zone of inhibition; 1:100 has a 15 mm zone of inhibition; and 1:1000 gives a 0 mm zone of inhibition. For Disinfectant B, a 1:10 dilution gives a 50 mm zone of inhibition; 1:100 has a 25 mm zone of inhibition; and 1:1000 gives a 10 mm zone of inhibition. Which disinfectant is most effective?
A) they are equally effective
B) cannot tell from the information given
C) B
D) A
B.
The disk-diffusion test is used to test disinfectants against Staphylococcus aureus. For Disinfectant A, a 1:10 dilution gives a 25 mm zone of inhibition; 1:100 has a 15 mm zone of inhibition; and 1:1000 gives a 0 mm zone of inhibition. For Disinfectant B, 1:10 dilution gives a 50 mm zone of inhibition; 1:100 has a 25 mm zone of inhibition; and 1:1000 gives a 10 mm zone of inhibition. Which disinfectant is bactericidal?
A) they are equally effective
B) A
C) cannot tell from the information given
D) B
Cannot tell from the information given.
You inoculate a nutrient agar plate with your fingers after washing your hands with water. Then you wash your hands with bar soap, rinse, and inoculate another nutrient agar plate. You repeat the handwashing with liquid soap and inoculate a third nutrient agar plate. The bar soap and liquid soap have the same chemical formulas. After incubating the plates, you record the amount of bacterial growth on a scale of - (no growth) to 3+ (maximum growth). Your results are: Water alone, +; Bar soap and water, 3+; Liquid soap and water, +. From these data, you can conclude that:
A) bacteria persist on bar soap.
B) soap kills bacteria.
C) liquid soap kills bacteria.
D) water kills bacteria.
Bacteria persist on bar soap.